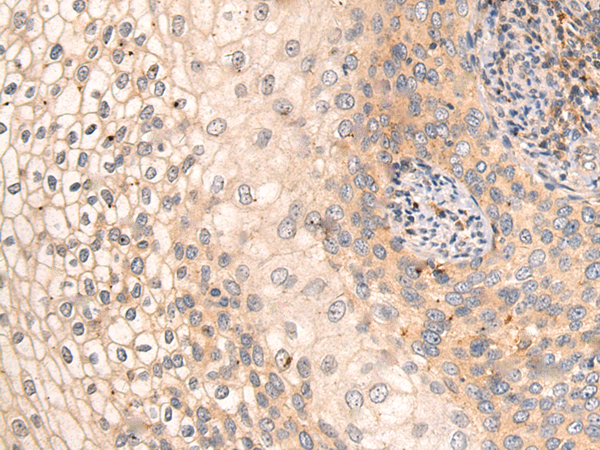
一抗

|
Background: |
This gene encodes a member of the ADAM (a disintegrin and metalloprotease domain) family. Members of this family are membrane-anchored proteins structurally related to snake venom disintegrins, and have been implicated in a variety of biological processes involving cell-cell and cell-matrix interactions, including fertilization, muscle development, and neurogenesis. This member is a subunit of an integral sperm membrane glycoprotein called fertilin, which plays an important role in sperm-egg interactions. |
|
Applications: |
ELISA, IHC |
|
Name of antibody: |
ADAM2 |
|
Immunogen: |
Fusion protein of human ADAM2 |
|
Full name: |
ADAM metallopeptidase domain 2 |
|
Synonyms: |
CT15; FTNB; PH30; CRYN1; CRYN2; PH-30b |
|
SwissProt: |
Q6P2G0 |
|
ELISA Recommended dilution: |
1000-2000 |
|
IHC positive control: |
Human thyroid cancer and Human liver cancer |
|
IHC Recommend dilution: |
15-50 |

 購物車
購物車 幫助
幫助
 021-54845833/15800441009
021-54845833/15800441009